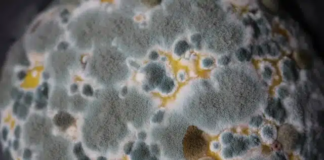

Tag: respiratory problems
മാരകമായ ഫംഗസ് വ്യാപിക്കാന് സാധ്യത; മനഷ്യരെയും ബാധിച്ചേക്കാമെന്നും മുന്നറിയിപ്പ്
മാരകമായ ഫംഗസ് വ്യാപിക്കാന് സാധ്യതയുണ്ടെന്നും ഇവ മനഷ്യരെയും ബാധിച്ചേക്കാമെന്നും മുന്നറിയിപ്പ്. വര്ധിച്ചുവരുന്ന താപനില കാരണം ആസ്പര്ജില്ലസ് ഫംഗസ് യൂറോപ്പ്, ഏഷ്യ, അമേരിക്ക എന്നിവിടങ്ങളിലെ ചില ഭാഗങ്ങളില് വ്യാപിക്കാന് സാധ്യതയുണ്ട്. ഈര്പ്പമുള്ള കാലാവസ്ഥയില് വളരുന്ന...